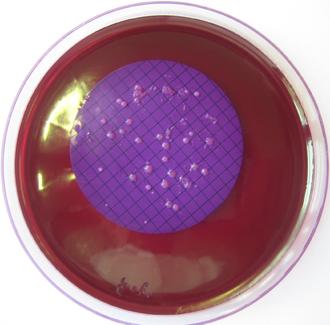

Inhaltsverzeichnis
Was sind E.Coli?
Wie schaffen es die E.Coli in unsere Trinkwasser-Installation?
Wie gefährlich sind E.Coli?
Wie erfolgt die Infektion?
Was sagt die Trinkwasserverordung?
Wie viele E.Coli sind zulässig?
Wie bekämpfen wir E.Coli?
Was sind coliforme Keime und E.Coli?
Bei coliformen Bakterien handelt es sich um eine Gruppe verschiedener Bakterien, Escherichia Coli ist eine davon. Deshalb wird bei der Trinkwasseruntersuchung die coliforme Keime als Indikatorparameter für E.Coli verwendet und auch gemeinsam untersucht. Neben diesem Keim bilden weitere Bakterien wie die Salmonellen, EHEC-Erreger und Enterobakterien die Familie der coliformen Keime. Für die Wasserhygiene sind die Escherichia Coli (E. Coli) die bedeutsamste Gruppe der coliformen Keime und unterliegen den Vorgaben der Trinkwasserverordnung.
E.Coli sind stäbchenförmige Bakterien, die sich mittels einer Geißel fortbewegen. Sie sind minimal, mit etwa 0,1 Prozent, im Darm von Menschen und Tieren, vorzufinden und produzieren unter anderem Vitamin K, das für wichtige Stoffwechselprozesse verantwortlich ist.
Es existieren jedoch zahlreiche humanpathogene (krankmachende) Stämme und weißen auf unhygienisches Trinkwasser hin.
Wie schaffen es die coliforme Keime in unsere Trinkwasser-Installationen?
Die möglichen Quellen der E.Coli im Trinkwasser sind vielfältig und lassen sich nicht immer klar zurückverfolgen. Die häufigsten Ursachen sind menschliche und tierische Ausscheidungen, somit weist das Bakterium auf eine fäkale Verunreinigung hin. Durch undichte Brunnendeckel können Keime von Tierkot in das Wasser gelangen.
Weitere Möglichkeiten für das Vorkommen sind undichte Rohrleitungen und mangelhaft gewartete Wasseraufbereitungsanlagen, wie Filter, Enthärtungsanlagen und Wassersprudler. Sie gelangen aber auch durch nicht ausreichend gewaschene Hände in die Geräte.
Zudem sind Leitungsstränge mit Stagnationswasser (stehendes Wasser) und Biofilmablagerungen eine gute Voraussetzung zum Überleben.
Wie gefährlich ist die Untergruppe Escherichia coli (E. coli)?
Sind die Bakterien erstmal im menschlichen Körper, verbreiten sie sich schnell. Innerhalb von nur 48 Stunden stoßen sie gesundheitsgefährdende Gase und Säuren ab.
Durchfall, Bauchfellentzündung, Wundinfektionen und Blinddarmentzündungen können verursacht werden. Andere E.Coli-Stämme verursachen Hirnhautentzündungen, Harnwegsinfektionen und können beim Eindringen in die Blutbahn sogar eine Sepsis (Blutvergiftung) herbeiführen.
Der gefährlichste Stamm ist der Enterohämorrhagische Escherchia coli (kurz: EHEC) welcher Organe, wie Niere und Hirn schwer schädigt und teilweise einen tödlichen Verlauf mit sich bringt.
Wie erfolgt die Infektion?
Die humanpathogenen Stämme lösen bei Verzehr Infektionen aus, wenn Sie in andere Bereiche des Körpers, als den Darm, gelangen. Nach der Infektion überträgt sich der Keim über den direkten und indirekten Kontakt mit kontaminierten Personen oder Gegenständen. Wundinfektionen beim Baden, Duschen oder Händewaschen treten ebenfalls auf.
Was sagt die Trinkwasserverordnung?
Das Gesundheitsamt kann diesen Parameter in Einzelfällen verlangen, dabei gilt der strenge Grenzwert von 0KBE/100ml.
Die Trinkwasserverordnung (TrinkwV) schreibt grundsätzlich keine regelmäßige Untersuchpflicht vor, jedoch müssen Hauseigentümer und Verwalter die Trinkwasser-Installationen jederzeit in einem mängelfreien Zustand und ohne jegliche hygienischen Beeinträchtigungen betreiben.
Daher empfehlen wir bei den regelmäßigen Legionellenuntersuchungen diese Parameter stichprobenartig analysieren zu lassen.
Wie viele Escherichia coli (E. coli) sind in der Trinkwasser-Installation zulässig?
Die Trinkwasserverordnung fasst die Parameter coliforme Bakterien und E.Coli zusammen. Da ein Befall dieser eine schwerwiegende Gefahr ist, gibt die Trinkwasserverordnung einen strengen Richtwert von 0 Koloniebildenden Einheiten pro 100ml vor (0KBE/100ml). Das heißt es dürfen keinerlei coliforme Keime im Trinkwasser sein.
Wie bekämpfen wir Escherichia coli (E. coli)?
Wenn coliforme Bakterien und dadurch auch E.Coli erst einmal im Trinkwasser nachgewiesen sind, sollte sofort gehandelt werden. Die Wahrscheinlichkeit ist sehr hoch, dass sich noch weitere Krankheitserreger angesiedelt haben. Wichtig ist, die Quelle der E.Coli-Verunreinigung zu finden und, wenn möglich, zu beseitigen.
Durch gezielte thermische oder chemische Desinfektion der gesamten Anlage können die Bakterien nach und nach abgetötet werden.